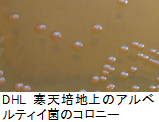

安全・安心情報
更新日:2025年3月21日
ここから本文です。
細菌部
細菌部は、大きく4つの項目についての試験検査、調査・研究を行なっています。
- 食中毒や感染症の発生に伴う細菌などの病原性微生物の検査および調査研究
- 食品や飲用水等における細菌や原虫等の検査および調査研究
- 環境中に生息する細菌などの検査および調査研究
- 県内の検査機関(厚生センター、食肉検査所など)に対する食品検査・感染症検査の研修指導、精度管理の実施
<ページ内リンク>
トピックス
- 2024年4月19日レジオネラ属菌の英文論文の掲載CorrelationbetweenbacterialmicrobiomeandLegionellaspeciesinwaterfrompublicbathfacilitiesby16SrRNAgeneampliconsequencing(別ウィンドウで開きます)
- 2025年3月21日ウエルシュ菌の英語論文の掲載(別紙リンク1)
- 2025年3月21日富山県で発生したボツリヌス症の家庭内集団発生例について(IASR)(別紙リンク2)
- 2025年3月21日富山県におけるA群溶血性レンサ球菌感染症の遺伝子解析とM1UK系統株の浸淫状況(IASR)(別紙リンク3)
行政および依頼検査
細菌部では、以下の検査業務を実施しています。(クリックすると該当箇所へ移動します。)
- 食品検査
- 水質検査
- 海水浴場水検査
- 原虫(クリプトスポリジウム、ジアルジア)による感染症
- 感染症法における「三類感染症」対応
- 腸管出血性大腸菌の遺伝子型別
- レジオネラ症患者の感染源調査
- 結核菌分子疫学調査
- CRE検査
- アニサキス検査
- クドア検査
- 病原細菌検出情報
- 溶レン菌レファレンス
- 感染症流行予測調査
検査依頼の様式はこちらからダウンロードしてください。
病原体定点医療機関用、病原体検査票ダウンロードページへ
申し訳ありませんが、個人的な検査依頼は受け付けておりませんのでご了承下さい。
食品検査
食品には、食品一般の成分規格、製造、加工及び調理基準、保存基準が定められていますが、それとは別に、個別に成分規格等が決められている食品があります。細菌部では、微生物に関する成分規格が定められている食品の一部について、検査を実施しています。
| 食品 | 対象微生物 | 基準 |
|---|---|---|
| 生食用食肉 (牛の食肉(内臓を除く)) |
腸内細菌科菌群 | 陰性 |
| 清涼飲料水 (ミネラルウォーター類) |
大腸菌群 | 陰性 |
|
ゆでがに |
腸炎ビブリオ |
陰性 |
| ゆでがに(冷凍) |
生菌数 大腸菌群 |
1,000,000以下/g 陰性 |
| ヒラメ(筋肉部位) | クドア・セプテンプンクタータ | 1,000,000以下/g |
食品別の規格基準についての詳細はこちら
厚生労働省ホームページ「食品-食品別の規格基準」(外部サイトへリンク)
水質検査
細菌部では、水道原水や海水浴場水の細菌検査を行っています。
当所では一般の方からの検査依頼は受け付けておりません。
飲料水の検査については、登録検査事業所に依頼できます。
飲料水の検査依頼についてはこちら
飲用井戸の衛生管理(富山県厚生部生活衛生課ホームページ)
| 対象 | 関係通知 | 検査項目 |
|---|---|---|
| 水道原水 | 富山県水道水質管理計画 | 水質管理目標設定項目 (従属栄養細菌数) |
| 浄水 | 水道法(水質基準) | 大腸菌 一般細菌数 |
| 海水浴場水 | 水浴場水質調査実施要領 | ふん便性大腸菌群数 腸管出血性大腸菌O-157 |
海水浴場水検査
富山県では、県内外から訪れる観光客の皆さまが安心して海水浴場を利用できるよう、県内の主要な海水浴場の水質検査を実施しています。細菌部ではそのなかの検査項目として、ふん便性大腸菌群数の定量試験と腸管出血性大腸菌O157の定性試験を実施しています。大腸菌は、植物や土壌などからも供給されますが、ヒトや動物の糞便汚染の指標として、ふん便性大腸菌群数を測定し、その数値により水質の格付けが行われ、海水浴シーズン前の7月には国から発表される海水浴「適・不適」判定の根拠の一つとなっています。
原虫(クリプトスポリジウム、ジアルジア)による感染症
 クリプトスポリジウムやジアルジアによる感染症は、日本での報告数は多くはありませんが、しばしば水系感染を原因とした集団感染を引き起こすことで知られています。症状は水溶下痢や腹痛で、嘔吐や発熱を伴うこともあります。細菌部では、クリプトスポリジウムやジアルジアを検出するための検査体制を整備しています。
クリプトスポリジウムやジアルジアによる感染症は、日本での報告数は多くはありませんが、しばしば水系感染を原因とした集団感染を引き起こすことで知られています。症状は水溶下痢や腹痛で、嘔吐や発熱を伴うこともあります。細菌部では、クリプトスポリジウムやジアルジアを検出するための検査体制を整備しています。
感染症法における「三類感染症」対応
感染症法(感染症の予防及び感染症の患者に対する医療に関する法律)で三類に指定されているコレラ・細菌性赤痢・腸管出血性大腸菌感染症・腸チフス・パラチフスの患者が発生した場合に、当部では原因菌の同定・毒素産生性・遺伝子検査・分子疫学的解析に加え、原因菌を国のレファレンスセンターへ送付しています。また、国からの解析報告書を医療機関などの関連機関へ還元しています。近年はこれらの感染症は輸入感染症といわれるように、感染源が国内ではなく、海外からの帰国者もしくは外国人からの報告例が増加しています。
腸管出血性大腸菌の発生状況についてはこちら
富山県感染症情報センター「腸管出血性大腸菌感染症」
- コレラ
コレラはコレラ菌(VibrioCholerae)を原因とし、激しい水様性(米のとぎ汁様)下痢を主訴とする感染症です。脱水状態に至らぬよう経口補水液の補給が有効とされています。コレラ菌の中でも、コレラ毒素(CorelaeToxin:CT)を産生するのは血清群O1またはO139のみです。当部では分離されたコレラ菌の毒素を産生する能力について、CT遺伝子の検出(PCR法)、あるいはCT産生性により確認します。富山県では2010年以降、コレラは1件も報告されていません。 - 細菌性赤痢
赤痢とは粘血便を伴う下痢症のことで、細菌性赤痢とアメーバ赤痢とがあります。細菌性赤痢は赤痢菌(Shigelladysenteriae,S.flexneri,S.boydii,S.sonnei)を原因とし、粘血便・発熱を主症状とする感染症です。1990年からほぼ毎年患者の報告がありますが、2010年代には減少傾向となっています。 - 腸チフス
チフスはチフス菌(SalmonellaTyphi)によって起こる感染症で、血便・発熱を主訴とします。チフスは1990年代にはほぼ毎年報告がありましたが、2000年から2023年までの報告数は4件と、激減しています。しかしながら、2024年には3件の報告がありました。 - パラチフス
パラチフスはパラチフスA菌(SalmonellaParatyphiA)によって起こる感染症で、血便・発熱を主訴とします。パラチフスもチフス同様、減少傾向を示しています。 - 腸管出血性大腸菌感染症
腸管出血性大腸菌感染症は、ベロ毒素を産生する腸管出血性大腸菌(EnterohemorrhagicEscherichiacoli,下線のアルファベットを並べてEHECとよぶことがあります)によって引き起こされる感染症で、腹痛、下痢のほか血便を伴う出血性大腸炎を主訴とします。また、この感染症では溶血性尿毒症症候群(HUS)や脳症などの重篤な合併症を引き起こすことがあります。
腸管出血性大腸菌の遺伝子型別
 細菌部では、O157などの腸管出血性大腸菌について、同じ菌かどうか迅速に鑑別する遺伝子型別法、Multilocusvariable-numbertandem-repeatanalysis(MLVA)を実施しています。従来3日かかる「遺伝子型別」をMLVAは1日以内で判定することができ、同一感染源由来の腸管出血性大腸菌による感染事例の迅速な検索をおこなうことが可能となります。
細菌部では、O157などの腸管出血性大腸菌について、同じ菌かどうか迅速に鑑別する遺伝子型別法、Multilocusvariable-numbertandem-repeatanalysis(MLVA)を実施しています。従来3日かかる「遺伝子型別」をMLVAは1日以内で判定することができ、同一感染源由来の腸管出血性大腸菌による感染事例の迅速な検索をおこなうことが可能となります。
レジオネラ症患者の感染源調査
 細菌部では、行政、医療機関と連携し、富山県内で発生したレジオネラ症患者からレジオネラ属菌を分離しています。厚生センターでは、患者が国内における主要な感染源である浴用施設を利用していた場合、施設の衛生管理状況を把握し、浴用水のレジオネラ属菌検査も実施しています。
細菌部では、行政、医療機関と連携し、富山県内で発生したレジオネラ症患者からレジオネラ属菌を分離しています。厚生センターでは、患者が国内における主要な感染源である浴用施設を利用していた場合、施設の衛生管理状況を把握し、浴用水のレジオネラ属菌検査も実施しています。
患者および浴用水からレジオネラ属菌が分離された場合には、細菌部で菌の遺伝子解析を実施し、その結果から患者の感染源を推定し、感染拡大の防止を図っています。
結核菌分子疫学調査
 富山県では、結核菌のまん延実態とその動向を把握することを目的として、結核患者の実地疫学調査とともに、結核菌のVariableNumberofTandemRepeat(VNTR)による分子疫学調査を実施しています。細菌部ではVNTRを実施し、集団感染の早期探知、伝播経路の解析に利用することで、結核の感染拡大防止に役立てています。
富山県では、結核菌のまん延実態とその動向を把握することを目的として、結核患者の実地疫学調査とともに、結核菌のVariableNumberofTandemRepeat(VNTR)による分子疫学調査を実施しています。細菌部ではVNTRを実施し、集団感染の早期探知、伝播経路の解析に利用することで、結核の感染拡大防止に役立てています。
CRE検査
 カルバペネム耐性腸内細菌科細菌(CRE)感染症の届出があった際、地域における薬剤耐性菌の流行状況を把握するために、耐性遺伝子の検出や薬剤感受性試験等の検査を実施しています。県内のCRE感染症の発生状況について、1年分を集計し年報に掲載しています。
カルバペネム耐性腸内細菌科細菌(CRE)感染症の届出があった際、地域における薬剤耐性菌の流行状況を把握するために、耐性遺伝子の検出や薬剤感受性試験等の検査を実施しています。県内のCRE感染症の発生状況について、1年分を集計し年報に掲載しています。
写真は、薬剤感受性試験結果です。細菌を全面に塗った寒天平板に薬剤を染み込ませたディスクを置いて18~20時間培養し、菌の発育度合を調べます。薬剤が効く場合は、ディスクの周りに菌が発育しません(青丸:感受性)。これを阻止円と呼びます。これに対し、薬剤が効かない場合にはディスクの周りにも菌が発育します(赤丸耐性)。薬剤に対する感受性・耐性を決める阻止円の大きさは薬剤ごとに決められているので、阻止円の大きさを測って判定します。
アニサキス検査
アニサキス食中毒は、アニサキス科の寄生虫の幼虫が、主に胃壁に刺入することで引き起こされます。食中毒の原因食品としては、魚の刺身、寿司や昆布〆で、原因物質は、アニサキス属およびシュードテラノバ属に分類される2属のアニサキス科線虫です。前者はイルカやクジラ、後者はアザラシなどの海生哺乳類を終宿主として、その胃に成虫が寄生しています。
富山県は、魚介類が豊富に取れる富山湾を有し、資源として重要です。富山湾の魚のアニサキスの汚染状況についての詳細な報告はありませんが、2018年1~6月にアニサキス食中毒患者の胃から摘出された虫体の同定検査を行ったので紹介します。29隻の虫体のうち、27隻がAnisakissimplexsensustrictoで2隻はA.pegreffiiでした。原因食品はサバが最も多く、それ以外にアジ、カツオ、イワシ、ブリと続きますが、13件は不明でした(詳細は以下のリンクから見ることができます)。このような結果は、日本海の魚種とアニサキス食中毒の発生状況を解析するうえで、貴重な情報になると考えています。
クドア検査
 クドアは、魚類、特にヒラメに多く寄生する粘液胞子虫(写真)です。ナナホシクドアと呼ばれるクドアセプテンプンクタータ(Kudoaseptempunctata)は、6~7つの花弁状の形態が特徴的です。生食用魚介類(ヒラメの刺身等)を喫食後、数時間後に一過性の嘔吐・下痢を発症します。この寄生虫による食中毒は喫食から発症までの時間が短いのが特徴です。食中毒対策としては、冷凍してから食べる、加熱して食べるなどが示されています。また、ヒラメの産地ではクドア食中毒対策を講じているようです。
クドアは、魚類、特にヒラメに多く寄生する粘液胞子虫(写真)です。ナナホシクドアと呼ばれるクドアセプテンプンクタータ(Kudoaseptempunctata)は、6~7つの花弁状の形態が特徴的です。生食用魚介類(ヒラメの刺身等)を喫食後、数時間後に一過性の嘔吐・下痢を発症します。この寄生虫による食中毒は喫食から発症までの時間が短いのが特徴です。食中毒対策としては、冷凍してから食べる、加熱して食べるなどが示されています。また、ヒラメの産地ではクドア食中毒対策を講じているようです。
病原細菌検出情報
県内10医療機関、富山市保健所、衛生研究所において、分離された起因菌の数を当所で集計しています。1年分の集計は富山県衛生研究所年報に掲載しています。
溶レン菌レファレンス
劇症型溶血性レンサ球菌感染症は、β溶血を示すレンサ球菌を原因とする感染症で、突然発病し急速に進行しショック状態から死に至ることもあります。近年、届出数が増加傾向にある感染症です。国立感染症研究所および地方衛生研究所からなる溶レン菌レファレンスセンターの東海北陸支部センターとして、支部管内で発生した劇症型溶血性レンサ球菌感染症の菌株を収集し、血清型別等の検査を行っています。また、集まった菌株を国立感染症研究所に送付し、解析結果を還元しています。
感染症流行予測調査
本事業は、我が国における集団免疫の現況把握、病原体の検索等の調査を行い、各種疫学資料と併せて検討し、予防接種事業の効果的な運用を図り、さらに、長期的視野に立ち総合的に疾病の流行を予測することを目的として実施されています。当所では県民の皆様にご協力いただきながら、百日咳、ジフテリア、破傷風の血清抗体価を測定しています。本調査結果は、富山県衛生研究所年報にて報告しています。
調査研究
サルモネラとカンピロバクターの生態学的研究
県内の医療機関の協力のもと収集したサルモネラ、カンピロバクターについて血清型、薬剤感受性の検査を実施しています。また調べた結果は医療機関へ還元しています。
アルベルティイ菌の保有状況調査
2003年に新しい細菌種として承認された下痢症を引き起こす菌、アルベルティイ菌について、県内で発生した感染事例の遡り調査や、食品からのアルベルティイ菌保有状況調査を行っています。
2003年に新しい細菌種として承認された下痢症を引き起こす菌、アルベルティイ菌について、県内で発生した感染事例の遡り調査や、食品からのアルベルティイ菌保有状況調査を行っています。
野生動物の下痢原生性大腸菌保有状況調査
野生動物について、腸内容物(糞便)の下痢原性大腸菌調査と病原性因子遺伝子の解析を行っています。これまでの調査から、イノシシ等の野生動物の狩猟後の解体に関しては衛生的処理が重要であることが示されました。
富山県で捕獲されたイノシシの病原細菌保有状況調査(2014-2016年)
(出典:日本食品微生物学会誌202037:61-68)(外部サイトへリンク)
衛研たよりNo121.ジビエをおいしく安全に食べるために(PDF:1,077KB)
CRE調査研究
県内で分離されたCRE感染症菌株のうち、カルバペネマーゼ遺伝子をもたない菌株(non-CPE株)について調査しています。non-CPE株については遺伝的背景についてほとんど知られていないため、そのような株について特徴が明らかになるか調査しています。
レジオネラ属菌に関する研究
 潜在的なレジオネラ症患者の実態を把握し、感染源を明らかにするため、県内の医療機関と連携し、前向き調査によりレジオネラ症疑い患者から積極的な喀痰検査を実施しています。
潜在的なレジオネラ症患者の実態を把握し、感染源を明らかにするため、県内の医療機関と連携し、前向き調査によりレジオネラ症疑い患者から積極的な喀痰検査を実施しています。
現在、環境水のレジオネラ属菌検査は、培養検査が広く普及していますが、結果が判明するまでに約1週間程度要します。迅速に結果を出すため、採水当日あるいは翌日に検査結果が判明する遺伝子検査法の構築に取り組んでいます。
これまでに道路の水たまり、河川水、ウオッシャー液などの環境検体から、レジオネラ属菌を分離し、感染源の可能性を示してきました。
肺炎球菌に関する研究
侵襲性肺炎球菌感染症の原因菌である肺炎球菌は、約100種類の血清型に分類されます。血清型によって侵襲性及び病型の違いが生じる機序を明らかにするため、培養細胞を用いて菌の侵襲性を評価しています。
地研ネットワークを利用した食品および人から分離されるサルモネラ、大腸菌、カンピロバクター等の薬剤感耐性の動向調査
薬剤耐性に対応するため、環境―動物―食品―人を包括するワンヘルスアプローチが重要であるとの考えから、食品と人から分離されたサルモネラ、大腸菌、カンピロバクターの薬剤耐性状況を、同じプロトコル、試薬、培地を用いて全国規模で調査を行っています。
腸管出血性大腸菌の塩基配列情報の整備
 次世代シークエンサーを用いて、腸管出血性大腸菌の塩基配列情報を取得し、塩基配列にふくまれる遺伝情報の整備を行っています。
次世代シークエンサーを用いて、腸管出血性大腸菌の塩基配列情報を取得し、塩基配列にふくまれる遺伝情報の整備を行っています。
業績
学術論文
2024年
- KanataniJ,FujiyoshiS,IsobeJ,KimataK,WatahikiM,MaenishiE,IzumiyamaS,Amemura-MaekawaJ,MaruyamaF,OishiK.CorrelationbetweenbacterialmicrobiomeandLegionellaspeciesinwaterfrompublicbathfacilitiesby16SrRNAgeneampliconsequencing.MicrobiolSpectr.2024Feb16:e0345923.
https://doi.org/10.1128/spectrum.03459-23(外部サイトへリンク)(別ウィンドウで開きます) - LeeK,IguchiA,TeranoC,HatayaH,IsobeJ,SetoK,IshijimaN,AkedaY,OhnishiM,IyodaS;EHECWorkingGroupinJapan.CombinedusageofserodiagnosisandOantigentypingtoisolateShigatoxin-producingEscherichiacoliO76:H7fromahemolyticuremicsyndromecaseandgenomicinsightsfromtheisolate.MicrobiolSpectr.2024Jan11;12(1):e0235523.
https://doi.org/10.1128/spectrum.02355-23(外部サイトへリンク)(別ウィンドウで開きます) - SaitoK,KimataK,WatahikiM,IsobeJ,KanataniJI,IkedaK,TakeuchiT,MatsuzakiC,OishiK. Investigation of an Outbreak of Clostridium perfringens in Toyama, Japan, 2023 Using Single-Nucleotide Polymorphism Analysis for Genotyping. Jpn J Infect Dis. 2025 Jan 23;78(1):47-50.
https://doi.org/10.7883/yoken.JJID.2024.189(外部サイトへリンク)(別ウィンドウで開きます) - KawaguchiA,NagaokaK,KawasujiH,KawagishiT,FuchigamiT,IkedaK,KanataniJI,DoiT,OishiK,YamamotoY.COVID-19 complicated with severe M1UK-lineage Streptococcus pyogenes infection in elderly patients: A report of two cases. Int J Infect Dis. 2024 Nov;148:107246.
https://doi.org/10.1016/j.ijid.2024.107246(外部サイトへリンク)(別ウィンドウで開きます) - 齋藤和輝,池田佳歩,清水ひな,大島萌愛,木全恵子,金谷潤一,大石和徳,田村恒介,柴山直美,高畠琢磨,森安祐成.富山県におけるA群溶血性レンサ球菌感染症の遺伝子型解析とM1UK系統株の浸淫状況.病原微生物検出情報 (IASR) 2025;46(1),19-20.
https://www.niid.go.jp/niid/ja/pneumococcal-m/group-a-streptococcus-iasrd/13117-539d03.html(外部サイトへリンク)(別ウィンドウで開きます) - 川岸利臣,土井智章,渕上貴正,波多野智哉,江嵜真佳,長岡健太郎,山本善裕,瀧波賢治,山田雅俊,齋藤和輝,木全恵子,大石和徳,黒田真弓,西尾恵美里,扇 のぞみ,川尻百香,竹内比佐子,妹尾充敏,見理 剛,油谷雅広,百瀬愛佳,岡田由美子,上間 匡.富山県で発生したボツリヌス症の家庭内集団発生例について.病原微生物検出情報 (IASR) 2025;46(1),20-22.
https://www.niid.go.jp/niid/ja/botulinum-m/botulinum-iasrd/13118-539d04.html(外部サイトへリンク)(別ウィンドウで開きます)
2023年
- NakamuraK,SetoK,LeeK,OokaT,GotohY,TaniguchiI,OguraY,MainilJG,PiérardD,HaradaT,EtohY,SaoriUedaS,HamasakiM,IsobeJ,KimataK,NarimatsuH,YatsuyanagiJ,OhnishiM,IyodaS,HayashiT.:Globalpopulationstructure,genomicdiversityandcarbohydratefermentationcharacteristicsofclonalcomplex119(CC119),anunderstudiedShigatoxin-producingE.coli(STEC)lineageincludingO165:H25andO172:H25.MicrobGenom.2023;9(3)
https://doi.org/10.1099/mgen.0.000959(外部サイトへリンク)(別ウィンドウで開きます) - DaichiMorita,HirokiArai,JunkoIsobe,EmiMaenishi,TakanoriKumagai,FumitoMaruyama,TeruoKuroda:Whole-GenomeandPlasmidComparativeAnalysisofCampylobacterjejunifromHumanPatientsinToyama,Japan,fro平方メートル015to2019.Microbiol.Spectrum.January/February2023;11:issue1
https://doi.org/10.1128/spectrum.02659-22(外部サイトへリンク)(別ウィンドウで開きます)
2022年
- TadayoshiIkebe,HitoshiOtsuka,KazukiChiba,YuKazawa,TakahiroYamaguchi,RumiOkuno,YoshimiDate,MariSasaki,JunkoIsobe,MakotoOhnishi,andYukihiroAkeda:Naturalmutationintheregulatorygene(srrG)influencesvirulence-associatedgenesandenhancesinvasivenessinStreptococcusdysgalactiaesubsp.equisimilisstrainsisolatedfromcasesofstreptococcaltoxicshocksyndrome:eBioMedicine2022;81:104133
https://doi.org/10.1016/j.ebiom.2022.104133(外部サイトへリンク)(別ウィンドウで開きます) - ChangB,TamuraK,FujikuraH,WatanabeH,TanabeY,KuronumaK,FujitaJ,OshimaK,MaruyamaT,AbeS,KawaharaK,NishiJ,KubotaT,KinjoY,SerizawaY,ShimbashiR,FukusumiM,ShimadaT,SunagawaT,SuzukiM,OishiK,andtheAdultIPDStudyGroup:PneumococcalMeningitisinAdultsin2014-2018afterIntroductionofPediatric13-valentPneumococcalConjugateVaccineinJapan.SciRep2022Feb23;12(1):3066.
https://doi.org/10.1038/s41598-022-06950-w(外部サイトへリンク)(別ウィンドウで開きます) - TamuraK,ChangB,ShimbashiR,WatanabeH,TanabeY,KuronumaK,OshimaK,MaruyamaT,FujitaJ,AbeS,KasaharaK,NishiJ,KubotaT,KinjoY,FujikuraH,FukusumiM,ShimadaT,SunagawaT,SuzukiM,YamamotoY,OishiK.:DynamicchangesinclinicalcharacteristicsandserotypedistributionofinvasivepneumococcaldiseaseamongadultsinJapanafterintroductionofthepediatric13-valentpneumococcalconjugatevaccinein2013–2019.Vaccine40:3338-44,2022.
https://doi.org/10.1016/j.vaccine.2022.04.062(外部サイトへリンク)(別ウィンドウで開きます)
2021年
- WatahikiM,chidaK,KanataniJ,KatoT,KimataK,IsobeJ,OishiK,TozakiK,SekiguchiK,HoritaY,MorishimaY,SugiyamaH:MolecularIdentificationofParasitesIsolatedfromtheStomachofPatientswithAnisakisFoodPoisoninginToyamaPrefecture,Japan,in2018.JpnJInfectDis2021.74時85分-86.
https://doi.org/10.7883/yoken.JJID.2020.289(外部サイトへリンク)(別ウィンドウで開きます) - NishidaR,NakamuraK,TaniguchiI,Murase,K,OokaT,OguraY,GotohY,ItohT,ToyodaA,MainilJ.G,PiérardD,SetoK,HaradaT,IsobeJ,KimataK,EtohY,HamasakiM,NarimatsuH,YatsuyanagiJ,KameyamaM,MatsumotoY,NagaiY,KawaseJ,YokoyamaE,IshikawaK,ShiomotoT,LeeK,KangD,Akashi,K,OhnishiM,IyodaS,HayashiT:Theglobalpopulationstructureandevolutionaryhistoryoftheacquisitionofmajorvirulencefactor-encodinggeneticelementsinShigatoxin-producingEscherichiacoliO121:H19.MicrobGeno平方メートル021.doi:10.1099/mgen.0.000716.
https://doi.org/10.1099/mgen.0.000716(外部サイトへリンク)(別ウィンドウで開きます) - KanataniJ,WatahikiM,KimataK,KatoT,UchidaK,KuraF,Amemura-MaekawaJ,IsobeJ.:DetectionofLegionellaspecies,theinfluenceofprecipitationontheamountofLegionellaDNA,andbacterialmicrobiomeinaerosolsfromoutdoorsitesnearasphaltroadsinToyamaPrefecture,Japan.BMCMicrobiol2021.21:215.
https://doi.org/10.1186/s12866-021-02275-2(外部サイトへリンク)(別ウィンドウで開きます) - KawaharaR,WatahikiM,MatsumotoY,UchidaK,NodaM,MasudaK,FukudaC,AbeY.AsanoY,OishiK.andShinomiyaH.:SubtypescreeningofblaIMPgenesusingbipartiteprimersforDNAsequencing.JpnJInfectDis2021.74:592-599.
https://doi.org/10.7883/yoken.JJID.2020.926(外部サイトへリンク)(別ウィンドウで開きます)
2020年
- Tadayoshiikebe,RumiOkuno,YoshikoKanda,MariSasaki,TakahiroYamaguchi,HitoshiOtsuka,YuKazawa,MiyukiSuzuki,HitomiOhya,KaoruUchida,MakotoOhnishi;WorkingGroupforBeta-HemolyticStreptococciinJapan:MolecularcharacterizationandantimicrobialresistanceofgroupAstreptococcusisolatesinstreptococcaltoxicshocksyndromecasesinJapanfro平方メートル013to2018.IntJMedMicrobiol.2021Apr;311(3):151496.
https://doi.org/10.1016/j.ijmm.2021.151496(外部サイトへリンク)(別ウィンドウで開きます) - 木全恵子,稲畑良,佐賀由美子,内田薫,加藤智子,金谷潤一,岩瀬忠行,綿引正則,小渕正次,磯部順子.イノシシからの志賀毒素産生性大腸菌の分離と分離株の特徴.日本食品微生物学会誌.2020.37時61分-68.
https://doi.org/10.5803/jsfm.37.61(外部サイトへリンク)(別ウィンドウで開きます) - KimataK,LeeK,WatahikiM,IsobeJ,OhnishiM,IyodaS:Globaldistributionofepidemic-relatedShigatoxin2encodingphagesamongenteroaggregativeEscherichiacoli.SciRep.,10.(2020)doi:10.1038/s41598-020-68462-9.
https://doi.org/10.1038/s41598-020-68462-9(外部サイトへリンク)(別ウィンドウで開きます) - Hara-KudoY,OhtsukaK,KonishiN,YoshidaT,IwabuchiK,HiratsukaT,NagaiY,KimataK,WadaH,YamazakiT,TsuchiyaA,MoriT,InagakiS,ShiraishiS,TerajimaJ.AninterlaboratorystudyonthedetectionmethodsforenterotoxigenicEscherichiacoliinvegetablesusingenterotoxingenescreeningandselectiveagarsforETEC-specificisolation.IntJFoodMicrobiol2020.
https://doi.org/10.1016/j.ijfoodmicro.2020.108832(外部サイトへリンク)(別ウィンドウで開きます) - TanakaD,FujiyoshiS,MaruyamaF,GotoM,KoyamaS,KanataniJ,IsobeJ,WatahikiM,SakatokuA,KagayaS,NakamuraS.:SizeresolvedcharacteristicsofurbanandsuburbanbacterialbioaerosolsinJapanasassessedby16SrRNAampliconsequencing.SciRep2020;10:12460.
https://doi.org/10.1038/s41598-020-68933-z(外部サイトへリンク)(別ウィンドウで開きます) - 磯部順子,金谷潤一,内田薫,木全恵子,前西絵美,綿引正則,大石和徳,石川智子,藤川美香,元井勇,瀧波賢治,宮崎英明,水木路男,守田万寿夫,吉田智子,田中恒久,土肥由美子,垣内孝子,高森徹,三井千恵子:富山県における百日咳の流行(2019).病原微生物検出情報(IASR)2020;41,125-127.
https://www.niid.go.jp/niid/ja/pertussis-m/pertussis-iasrd/9767-485d01.html(外部サイトへリンク)(別ウィンドウで開きます) - 綿引正則,内田薫,木全恵子,金谷潤一,磯部順子,大石和徳,高本恭子,佐々木一成,高橋慎太郎,得田和彦,押田尚宏:医療関連感染を疑ったNDM-5メタロ-β-ラクタマーゼ産生大腸菌を保菌していた2症例(富山県).病原微生物検出情報(IASR)2020;41,86.
https://www.niid.go.jp/niid/ja/cre-m/cre-iasrd/9636-483d01.html(外部サイトへリンク)(別ウィンドウで開きます) - OzuruR,WakaoS,TsujiT,OharaN,MatsubaT,AmuranYM,IsobeJ,IinoM,NishidaN,MatsumotoS,IwadateK,KonishiN,YasudaK,TashiroK,HidaM,YadoiwaA,KatoS,YamashitaE,MatsumotoS,KurozawaY,DezawaM,FujiiJ.:RescuefromStx2-ProducingE.coli-AssociatedEncephalopathybyIntravenousInjectionofMuseCellsinNOD-SCIDMice.MolTher2020;28:100-118.
https://doi.org/10.1016/j.ymthe.2019.09.023(外部サイトへリンク)(別ウィンドウで開きます) - NakamuraK,MuraseK,SatoP.M.,ToyodaA,ItohT,MainilGJ,PiérardD,YoshinoS,KimataK,IsobeJ,SetoK,EtohY,NarimatsuH,SaitoS,YatsuyanagiS,LeeK,IyodaS,OhnishiM,OokaT,GotohY,OguraY,HayashiT:DifferentialdynamicsandimpactsofprophagesandplasmidsonthepangenomeandvirulencefactorrepertoiresofShigatoxin-producingEscherichiacoliO145:H28.MicrobGenom.2020;6.
https://doi.org/10.1099/mgen.0.000323(外部サイトへリンク)(別ウィンドウで開きます) - 綿引正則,内田薫,金谷潤一,加藤智子,木全恵子,磯部順子,大石和徳,東崎香奈,關口健治,堀田和,森嶋康之,杉山広:アニサキス食中毒事例から摘出された胃寄生虫体の分子同定結果(富山県).病原微生物検出情報(IASR)2020;41,34.
https://www.niid.go.jp/niid/ja/anisakis-m-44/anisakis-iasrd/9433-480d02.html(外部サイトへリンク)(別ウィンドウで開きます) - WatahikiM,KawaharaR,SuzukiM,AokiM,UchidaK,MatsumotoY,KumagaiY,NodaM,MasudaK,FukudaC,HaradaS,SenbaK,SuzukiM,MatsuiM,SuzukiS,ShibayamaK,ShinomiyaH:Single-TubeMultiplexPolymeraseChainReactionfortheDetectionofGenesEncodingEnterobacteriaceaeCarbapenemase.JpnJ.Infect.Dis2020;73:166-172.
https://doi.org/10.7883/yoken.JJID.2019.041(外部サイトへリンク)(別ウィンドウで開きます)
学会発表
2024年
- 金谷潤一,磯部順子,木全恵子,池田佳歩,齋藤和輝,前西絵美,大石和徳:分子疫学解析による富山県内のレジオネラ症患者の実態把握と感染源調査,第97回日本細菌学会総会,札幌市,令和6.8.7-9
- 齋藤和輝,木全恵子,磯部順子,金谷潤一,池田佳歩,前西絵美,竹内祟,松崎千春,大石和徳:2023年に富山県内で発生したウエルシュ菌食中毒事例におけるNGSを用いたSNP解析,第97回日本細菌学会総会,札幌市,令和6.8.7-9
- 池田佳歩,磯部順子,前西絵美,木全恵子,金谷潤一,齋藤和輝,池辺忠義,明田幸宏,大石和徳:高齢者施設居住者の腸管内における溶血性レンサ球菌の保菌状況調査,第97回日本細菌学会総会,札幌市,令和6.8.7-9
- Kanatani J, Kimata K, Saito K, Ikeda K, Oshima M, Shimizu H, Oishi K. Prevalence and molecular epidemiology of Le-gionnaires' disease in Toyama Prefecture, Japan. The 8th ESGLI Meeting, Dresden, October 24-25, 2024.
2023年
- 木全恵子,前西絵美,金谷潤一,佐賀由美子,綿引正則,磯部順子,大石和徳:イノシシから分離された志賀毒素産生性大腸菌(STEC)の解析,第25回腸管出血性大腸菌感染症研究会,岐阜市,令和5.9.12-13
- 齋藤和輝,木全恵子,磯部順子,金谷潤一,大石和徳:2023年に富山県内で発生したウエルシュ菌食中毒事例の解析,第93回日本感染症学会西日本地方会学術集会,富山市,令和5.11.9-11
- 伊藤宏保,狩野惠彦,東慶之介,脇田明宏,浦田孝之,齋藤和輝,金谷潤一,磯部順子,大石和徳:急激な経過で死亡した劇症型溶血性レンサ球菌感染症の一例と菌の侵入門戸に関する考察,第93回日本感染症学会西日本地方会学術集会,富山市,令和5.11.9-11
- 金谷潤一:富山県内の入浴施設における水検体のレジオネラ属菌検出状況(2012~2021年),令和 5年度北陸公衆衛生学会,富山市,令和5.11.27
- Kanatani J, Maenishi E, Ikeda K, Kimata K, Saito K, Isobe J, Oishi K. Increased transcytosis of Streptococcus pneumoniae serotypes 10A and 23A across human brain microvascular endothelial cells: a possible implication of developing bacterial meningitis. 4 th Asian Pneumococcal Symposium,Korea,December 7-8, 2023.
2022年
- Jun-ichiKanatani,SoFujiyoshi,JunkoIsobe,KeikoKimata,MasanoriWatahiki,EmiMaenishi,ShinjiIzumiyama,JunkoAmemura-Maekawa,FumitoMaruyama,andKazunoriOishi:Characterizationofbacterialmicrobiomeinwaterfrompublicbath,especiallyfocusingonLegionella.The10thInternationalConferenceonLegionella.Yokohama,Japan.September20-24,2022
- 磯部順子,前西絵美,木全恵子,金谷潤一,綿引正則,佐賀由美子,谷英樹,大石和徳:富山県で捕獲されたイノシシのエルシニア属菌の保有状況.第43回日本食品微生物学会学術総会,東京都江戸川区,令和4年9.29-30
- 中村圭司,勢戸和子,磯部順子,林哲也:Insertionsequence(IS)–excisionenhancer(IEE)を介したISの切り出しによるSTECO121:H19の乳糖分解性に世の変化における乳糖の関与.第24回腸管出血性大腸菌感染症研究会,川崎市.令和4.10.13-14
- 綿引正則,磯部順子,原田哲也,木全恵子,金谷潤一,小坂真紀,前西絵美,伊豫田淳,大石和徳:16SリボゾームRNAとipaHを対象とした侵入性大腸菌と赤痢菌を鑑別するPCR法の開発とその評価.第24回腸管出血性大腸菌感染症研究会,川崎市,令和4.10.13-14
- 原田哲也,磯部順子,小西典子,江藤良樹,泉谷秀昌,伊豫田淳:赤痢菌と腸管侵入性大腸菌を鑑別するための分子疫学的手法の確立.第24回腸管出血性大腸菌感染症研究会,川崎市,令和4.22.10.13-14
- 中村佳司,勢戸和子,磯部順子,谷口愛樹,後藤恭宏,林哲也:Insertionsequence(IS)-excisionenhancer(IEE)を介したISの切り出しによる志賀毒素産生性大腸菌O121:H19の乳糖分解性の再活性化.第74回日本細菌学会九州支部総会,長崎市,令和4.9.9-10.
- 金谷潤一,前西絵美,田村恒介,磯部順子,大石和徳:肺炎球菌の経細胞間移動能および細胞内侵入能の評価.第96回日本細菌学会総会,姫路市,令和5.3.16-18
- 磯部順子,木全恵子,金谷潤一,原田哲也,伊豫田淳,大石和徳:腸管侵入性大腸菌と赤痢菌を鑑別するリアルタイムPCR法の開発とその評価.第96回日本細菌学会総会,姫路市,令和5.3.16-18
- 木全恵子,金谷潤一,磯部順子,大石和徳:イノシシから分離された志賀毒素産生性大腸菌(STEC)の解析.第96回日本細菌学会総会,姫路市,令和5.3.16-18
2021年
- 中村佳司,勢戸和子,磯部順子,林哲也:挿入配列の切り出しによる大腸菌O121:H19の乳糖分解性の再活性化.第95回日本細菌学会総会.東京都新宿区.令和4.3.29-3.31
- 荒井大樹,森田大地,磯部順子,前西絵美,熊谷孝則,丸山史人,黒田照夫:ヒト患者由来Campylobacterjejuniの薬剤感受性とレジストーム解析.第95回日本細菌学会総会,東京都新宿区,令和4.3.29-3.31
- 木全恵子,磯部順子,綿引正則,前西絵美,佐賀由美子:富山県におけるイノシシの志賀毒素産生性大腸菌の地域定着性の解析.第56回富山県公衆衛生学会,富山市,令和4.2.18
- 綿引正則,内田薫,中村雅彦,金谷潤一,磯部順子,木全恵子,大石和徳,高本恭子,佐々木一成,高橋慎太郎,得田和彦:同一患者由来,長期保菌後の病原性大腸菌ST405から検出された一塩基多型.第50回薬剤耐性菌研究会,伊豆の国市,令和3.12-13
2020年
- 金谷潤一,磯部順子,大石和徳:富山県のレジオネラ症対策における衛生研究所の取り組みと地域連携,第94回日本感染症学会総会・学術講演会,東京都港区,令和2.4.16-18
- 松本昌門,泉谷秀昌,四宮博人,磯部順子,小西典子,河村真保,勢戸和子,皆川洋子,大西真:地方衛生研究所に対する外部精度管理体制と研修システムの構築.第93回日本細菌学会総会,名古屋市,R2.2.19-2.21
- 木全恵子,李謙一,綿引正則,磯部順子,大西真,伊豫田淳:志賀毒素産生性腸管凝集性大腸菌(Stx-EAEC)O86における集団感染由来O104:H4と同一のStx2aファージの獲得.第93回日本細菌学会総会,名古屋市,R2.2.19-2.21
研修・指導
- 富山県厚生センター・富山市保健所職員「細菌・ウイルス検査法研修」
- Vpcamp:衛生研究所における獣医師の業務と役割の理解
講義
- 富山県消防学校救急科、特殊災害科
- きらめきエンジニア事業
お問い合わせ
関連情報
より良いウェブサイトにするためにみなさまのご意見をお聞かせください
